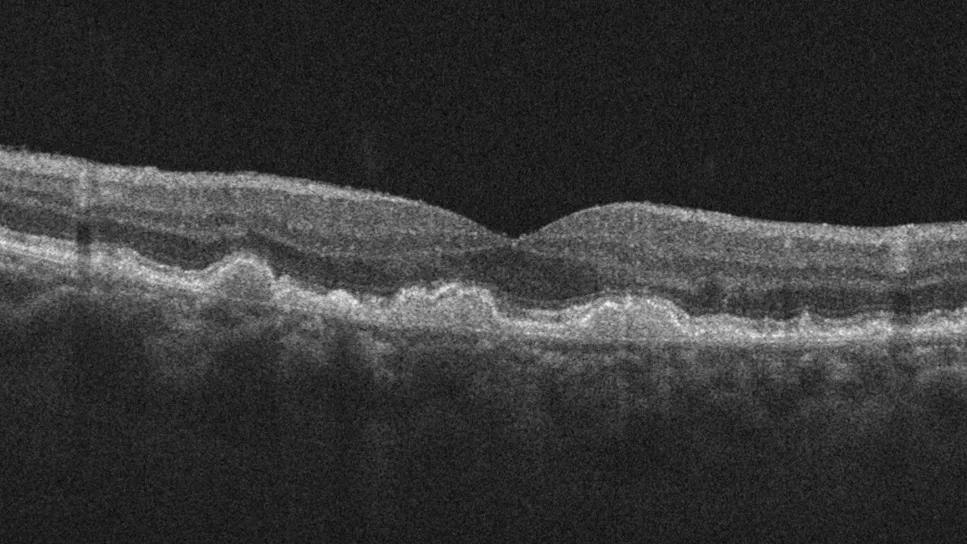

Early data show risk is 73% higher in patients with lupus, 40% higher in patients with rheumatoid arthritis
Image content: This image is available to view online.
View image online (https://assets.clevelandclinic.org/transform/9f7d078d-18ad-4440-a56f-78fe95c290e5/scan-showing-dry-amd)
Macular degeneration
Patients are more likely to develop age-related macular degeneration (AMD) if they have a systemic immune-mediated inflammatory disease, according to new research at Cleveland Clinic Cole Eye Institute. Findings suggest a higher risk of AMD in patients with lupus, rheumatoid arthritis, inflammatory bowel disease and other autoimmune conditions.
Advertisement
Cleveland Clinic is a non-profit academic medical center. Advertising on our site helps support our mission. We do not endorse non-Cleveland Clinic products or services. Policy
“AMD is a multifactorial disease,” says senior author Katherine E. Talcott, MD, a vitreoretinal surgeon at the Cole Eye Institute. “Genetics plays a role as do environmental factors like diet and smoking. Then there’s an inflammatory component that isn’t well understood. That’s what we were trying to learn more about with this study.”
The recent study was proposed and led by Priya Shukla, a student at Cleveland Clinic Lerner College of Medicine who is spending her research year at the Cole Eye Institute.
“There was a lot of excitement when new complement-inhibitor medications [pegcetacoplan and avacincaptad pegol] were introduced for treating geographic atrophy, an advanced form of AMD,” says Shukla. “However, these drugs worked to varying degrees in patients in clinical trials. We started wondering if patients with underlying complement deficiency might have better responses to those medications.”
Increased complement activation is seen in advanced AMD as well as many autoimmune diseases.
The first step in exploring the team’s question about treatment response was to assess the association between AMD and autoimmune disease. Findings from the recent study were published in Ophthalmology Retina.
Researchers studied more than 200,000 people with AMD and more than 200,000 people with an age-related cataract but no AMD listed in a national database that contained records of general healthcare as well as ophthalmology care. They compared patients with and without autoimmune disease and found higher relative risk (RR) of AMD in patients who had:
Advertisement
The reason for this increased risk is still undetermined, but the research team has a hypothesis.
“We suspect that patients with an autoimmune disease are in a pro-inflammatory state for years and years and are more likely to have a robust inflammatory response in their eyes as well,” explains Shukla.
According to Dr. Talcott, physicians who see patients with autoimmune disease should consider a lower threshold for referring patients to an ophthalmologist for vision complaints.
“It may be wise to advise these patients to have regular ophthalmology evaluations even if they’re younger and don’t have other AMD risk factors,” says Dr. Talcott. “It’s hard to limit vision loss in advanced AMD, but there are interventions to help slow disease progression in its early and intermediate stages and counseling for signs of disease progression.”
While AMD is typically diagnosed in people after age 60, lupus is often diagnosed before age 50, for example. Studies have found drusen-like deposits in the retinas of younger patients with lupus (average age 42) as well as those with inflammatory bowel disease (average age 48).
How early in life these patients should be seen by an ophthalmologist is the next question to be explored. The research team currently is studying if patients with autoimmune disease develop AMD earlier in life.
Their findings may help direct recommendations for earlier screening in this population. They also may lead to future studies on how AMD appears on imaging in these patients, if their disease can be targeted with different medications and if new medications need to be developed.
Advertisement
In the meantime, Shukla will continue her medical education, planning to graduate from the Lerner College of Medicine in 2025 before beginning an ophthalmology residency.
“It is remarkable how much Priya has been able to achieve so early in her research year,” says Dr. Talcott. “She developed this innovative research project and has done a great job seeing it to fruition. It’s exciting for us at the Cole Eye Institute to help budding clinician-scientists like her launch their promising careers.”
Advertisement
Advertisement
New insights on effectiveness in patients previously treated with other anti-VEGF drugs
Evidence mounts that these diabetes and obesity drugs may protect eyes, not endanger them
CFH gene triggers the eye disease in white patients but not Black patients
A primer on sustained release options
Study explores association between sleep aid and eye disease
Switching medications may decrease treatment burden and macular fluid
Why retina specialists should get comfortable with this imaging tool
How to use? Consider starting during the acute attack and seek patient preferences for chronic use